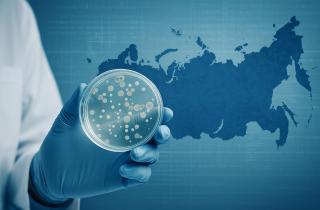
ПНИПУ возглавил рейтинг по цитируемости в научно-популярных СМИ

Дмитрий Корнилов
Дмитрий Корнилов родился в 1982 году в Вологде. В 2004 году окончил РАНХиГС при Президенте РФ по специальности "Государственное и муниципальное управление".
Ключевые компетенции и профессиональный опыт:
- Инфраструктурное управление: Более 15 лет стажа в муниципальных структурах, включая работу в должности заместителя главы администрации по вопросам ЖКХ, транспорта и городского планирования.
- Цифровизация и Smart City: Руководство проектами по внедрению систем автоматизированного управления городским хозяйством и созданию цифровой инфраструктуры взаимодействия власти с населением.
- Стратегическое развитие: Разработка программ комплексного благоустройства общественных пространств и внедрение механизмов инициативного бюджетирования.
Специализируется на вопросах устойчивого регионального развития и повышения эффективности работы органов местного самоуправления. Экспертное мнение Дмитрия Корнилова основано на масштабном опыте реализации государственных программ и глубоком понимании специфики управления российскими регионами.

Материалы автора (168)
 2025-11-22 00:26.00
2025-11-22 00:26.00
В Тюмени усилили контроль за водоемами из-за угрозы выхода на тонкий лед. Спасатели проводят профилактическую акцию «Безопасный лед».
Читать полностью » 2025-11-21 23:26.00
2025-11-21 23:26.00
Пермский Политех вновь занял первое место в России по цитируемости в научно-популярных СМИ, опередив ведущие столичные вузы.
Читать полностью » 2025-11-21 22:19.00
2025-11-21 22:19.00
Рост зимних бронирований в Крыму меняет привычный сезонный баланс: туристы активнее выбирают южнобережные отели и формируют один из лучших сезонов последних лет.
Читать полностью » 2025-11-21 20:54.00
2025-11-21 20:54.00
В 2025 году жители Пермского края начали чаще покупать спортивные товары и одежду к Новому году. Осенью интернет-трафик на спортивные магазины вырос на 21%.
Читать полностью » 2025-11-21 19:33.00
2025-11-21 19:33.00
На медиофоруме в Сургуте губернатор Югры рассказал о планах обновить три аэропорта округа, затронув реконструкцию терминалов, полос и ключевых инфраструктурных объектов.
Читать полностью » 2025-11-21 19:26.00
2025-11-21 19:26.00
Москвичей призвали задуматься о своих привычках потребления и сделать шаги к осознанному подходу: от сокращения покупок до правильной утилизации отходов.
Читать полностью » 2025-11-21 18:40.00
2025-11-21 18:40.00
Губернатор Югры Руслан Кухарук опроверг слухи о переносе столицы региона в Сургут, подтвердив важность обоих городов в развитии округа.
Читать полностью » 2025-11-21 18:20.00
2025-11-21 18:20.00
Тюменьстат зафиксировал снижение цен на популярные марки топлива в ХМАО, однако часть видов бензина и дизель показали обратную динамику — картина оказалась неоднородной.
Читать полностью » 2025-11-21 10:16.00
2025-11-21 10:16.00
В Челябинской области в 2025 году лидируют имена Александр и София. Какие имена стали самыми редкими для новорожденных?
Читать полностью » 2025-11-21 09:32.00
2025-11-21 09:32.00
В Челябинске за 2025 год курьеры получали более 643 тысяч рублей чаевых. Как изменился объем благодарности по месяцам и когда чаевых стало больше всего?
Читать полностью » 2025-11-21 09:16.00
2025-11-21 09:16.00
В 2025 году объем инвестиций в Ямале сократится на 20%, однако в будущем году ожидается рост, который компенсирует текущий спад. Какие планы у региона на будущее?
Читать полностью » 2025-11-21 08:36.00
2025-11-21 08:36.00
На Ямале перед новогодними праздниками увеличился спрос на подработки. Какие вакансии востребованы в регионе — читайте в нашем обзоре.
Читать полностью »
